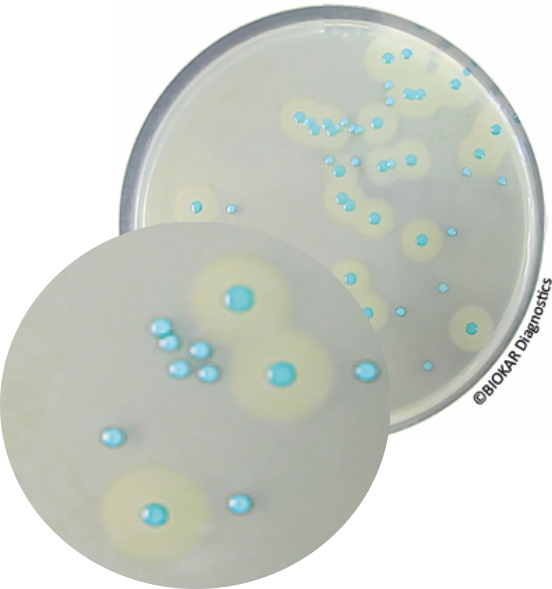

COMPASS® Listeria Agar
COMPASS® Listeria Agar
Kromojenik (Chromogenic) Listeria Agar
Bütün gıdalarda ve çevresel örneklerde Listeria monocytogenes ve diğer Listeria spp. türlerinin saptanması ve sayımı için geliştirilmiştir.
Kolay - Hızlı - Basit - Ekonomik
- Bütün laboratuvarlarda kolayca uygulanabilir bir protokoldür.
- 40 saatte negatif sonuç verir.*
- L.monocytogenes türleri opak bir hale ile çevrilmiş mavi koloniler oluşturur.
- Diğer Listeria spp.'ler ise halesiz mavi koloniler oluşturur.
Performans
- Valide yöntem kullanılırsa ikinci zenginleştirme basamağına gerek yoktur.
- Mükemmel seçicilik ile okuma ve optimal sayım sağlar.
Güvenilir
- ISO 11290-1/A1 ve 11290-2/A1 standardı referans alınarak ISO 16140 alternatif metot validasyon standardı kapsamında AFNOR tarafından BKR 23 / 02-11 / 02 (tespit) ve BKR 23 / 05-12 / 07 (sayım) referans numaraları ile valide edilmiştir.
- İlgili referans standartlarında belirtilen içeriği birebir karşılamaktadır.
*Valide yöntem gereği Half Fraser Broth ön zenginleştirme besiyeri önceden ısıtılmalıdır.
